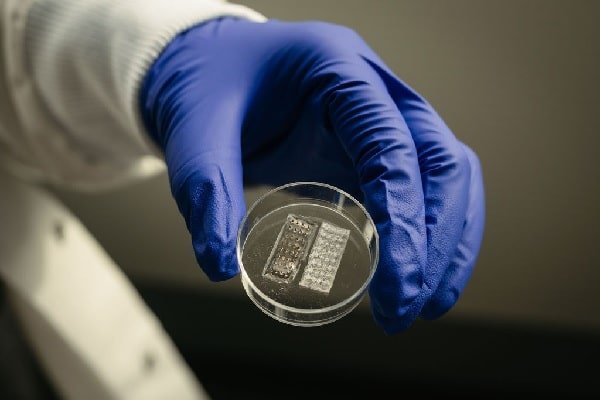

Pixabay
Fonte
Universidade Federal de Santa Catarina
Publicação Original
Áreas
Compartilhar
Resumo
Um novo estudo analisou a bioacumulação de arsênio e metais pesados em ostras no Brasil e sua relação com a presença de bactérias resistentes como Klebsiella pneumoniae, Escherichia coli e Citrobacter telavivensis.
Os pesquisadores destacaram que os metais podem selecionar genes de resistência nas bactérias que compartilham o ambiente marinho com as ostras e são filtradas por elas. Portanto, os metais favorecem a sobrevivência e a proliferação de bactérias que possuem mecanismos de resistência tanto contra químicos quanto contra antibióticos.
Embora o estudo não avalie o risco imediato para o consumidor e não indique que ostras não possam ser consumidas, os pesquisadores apontam para a necessidade de preservação da qualidade ambiental.
Foco do Estudo
Estudo
Um estudo publicado na revista científica Food Research International analisou a bioacumulação de arsênio em ostras prontas para consumo no Brasil e sua associação com bactérias resistentes.
Com foco em Cananéia, Santos, São Paulo, Peruíbe e em Florianópolis, a análise não abrangeu o risco imediato para o consumidor dos moluscos, mas apontou questões relevantes sobre ambientes contaminados e suas consequências.
O estudo identificou altas concentrações de arsênio total nas ostras e a presença de cepas bacterianas resistentes a antibióticos de prioridade crítica da OMS, incluindo Klebsiella pneumoniae, Escherichia coli e, pela primeira vez em frutos do mar, Citrobacter telavivensis, uma bactéria oportunista descrita em 2021.
“O que a pesquisa traz é uma contribuição científica para compreendermos melhor os fatores ambientais que podem impactar a cadeia produtiva de alimentos de origem marinha, como é o caso das ostras”, disse Gustavo Rocha, doutorando e pesquisador do Laboratório de Microbiologia Molecular Aplicada da Universidade Federal de Santa Catarina (UFSC).
O pesquisador explicou que o ambiente sofre com o que se chama de ‘pressão seletiva’. Isso ocorre, de acordo com ele, quando a sobrevivência de certos organismos é favorecida pelo meio em detrimento a outros. “No caso das ostras e do ambiente marinho, a presença constante de contaminantes como antibióticos e elementos químicos, como o arsênio, funciona como essa pressão. Ou seja, só sobrevivem as bactérias que conseguem resistir a esses compostos”.
A iniciativa do estudo partiu do Dr. Nilton Lincopan, professor do Instituto de Ciências Biomédicas da Universidade de São Paulo (ICB-USP), e de seu orientando de doutorado, Felipe Vásquez-Ponce. O professor é fundador e idealizador da rede OneBR – One Health Brazilian Resistance Project, uma plataforma nacional de vigilância epidemiológica genômica. A proposta, de acordo com Gustavo Rocha, é integrar dados e especialistas de diferentes áreas conectando saúde humana, animal e do meio ambiente.
Os pesquisadores explicaram que o arsênio e outros metais pesados podem selecionar genes de resistência nas bactérias que compartilham o ambiente marinho com as ostras e são filtradas por ela. “Ostras são organismos filtradores e, por isso, têm a capacidade de acumular contaminantes presentes no ambiente, como metais pesados e microrganismos”, explicou Gustavo Rocha.
Também participaram do estudo pesquisadores do Instituto de Química, da Faculdade de Ciências Farmacêuticas e do Instituto de Geociências da USP; do Instituto de Ciências Ambientais, Químicas e Farmacêuticas da Universidade Federal de São Paulo (Unifesp); do Instituto de Pesquisas Tecnológicas (IPT) e do Instituto de Pesquisas Energéticas e Nucleares (IPEN).
Os resultados reforçam a necessidade de atenção contínua à qualidade das águas utilizadas na maricultura, não apenas sob os critérios microbiológicos tradicionais, mas também considerando a presença de contaminantes químicos que podem favorecer desequilíbrios microbiológicos no ambiente
Resultados
Os resultados indicaram que as altas concentrações de arsênio total refletem um ambiente ao redor dessas áreas de cultivo exposto a níveis elevados do contaminante.
A presença de elementos químicos como o arsênio no ambiente atua favorecendo a sobrevivência e a proliferação de bactérias que possuem mecanismos de resistência tanto a químicos quanto a antibióticos.
Gustavo Rocha destacou que, com o tempo, essas bactérias se tornam dominantes e podem transferir seus genes de resistência para outras. “Assim, mesmo que as áreas sejam classificadas como seguras sob critérios tradicionais, essas bactérias continuam circulando e se espalhando, o que representa um risco silencioso”, destacou o professor.
Embora o estudo não avalie o risco imediato para o consumidor e não sugira ou indique que ostras não possam ser consumidas, ele aponta para a necessidade de preservação da qualidade ambiental.
O estudo não aponta um risco direto ao consumo, mas sim uma problemática ambiental mais ampla, que deve ser acompanhada com responsabilidade e cuidado por todos os setores envolvidos, incluindo ciência, governo e sociedade
Em suas publicações, o Portal SciAdvances tem o único objetivo de divulgação científica, tecnológica ou de informações comerciais para disseminar conhecimento. Nenhuma publicação do Portal SciAdvances tem o objetivo de aconselhamento, diagnóstico, tratamento médico ou de substituição de qualquer profissional da área da saúde. Consulte sempre um profissional de saúde qualificado para a devida orientação, medicação ou tratamento, que seja compatível com suas necessidades específicas.
Autores/Pesquisadores Citados
Instituições Citadas
Publicação
Acesse o resumo do artigo científico (em inglês).
Acesse a revista científica Food Research International (em inglês).
Mais Informações
Acesse a notícia original completa na página da Universidade Federal de Santa Catarina.
Notícias relacionadas
Universidade McMaster

Universidade de Helsinque
Universidade Regional do Cariri





